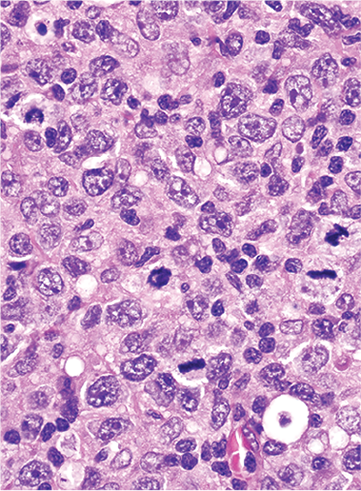

Issue Archive
Table of Contents
BLOOD COMMENTARIES
PERSPECTIVE
Developing a classification of hematologic neoplasms in the era of precision medicine
We present the new International Consensus Classification (ICC) of myeloid and lymphoid neoplasms, introduced by a Perspective by Sehn and Cazzola. This classification better integrates genomic information to allow therapy to be more easily tailored to targeted agents. In the Perspective, the authors propose that the ICC be adapted to an interactive web-based portal to allow more nimble modification to reflect new discoveries and improve diagnostic, prognostic, and predictive information.
SPECIAL REPORTS
International Consensus Classification of Myeloid Neoplasms and Acute Leukemias: integrating morphologic, clinical, and genomic data
We present the new International Consensus Classification (ICC) of myeloid and lymphoid neoplasms, introduced by a Perspective by Sehn and Cazzola. This classification better integrates genomic information to allow therapy to be more easily tailored to targeted agents. In the Perspective, the authors propose that the ICC be adapted to an interactive web-based portal to allow more nimble modification to reflect new discoveries and improve diagnostic, prognostic, and predictive information.
The International Consensus Classification of Mature Lymphoid Neoplasms: a report from the Clinical Advisory Committee
We present the new International Consensus Classification (ICC) of myeloid and lymphoid neoplasms, introduced by a Perspective by Sehn and Cazzola. This classification better integrates genomic information to allow therapy to be more easily tailored to targeted agents. In the Perspective, the authors propose that the ICC be adapted to an interactive web-based portal to allow more nimble modification to reflect new discoveries and improve diagnostic, prognostic, and predictive information.
CLINICAL TRIALS AND OBSERVATIONS
Prophylactic tranexamic acid in patients with hematologic malignancy: a placebo-controlled, randomized clinical trial
Clinical Trials & Observations
The antifibrinolytic agent tranexamic acid (TXA) is often used to prevent bleeding in patients with hemorrhagic disorders or platelet dysfunction, and there has been speculation that it might prevent bleeding in patients with thrombocytopenia. Gernsheimer and colleagues report on a randomized double-blind study of TXA vs placebo for patients with hematologic malignancy and treatment-related thrombocytopenia. The authors confirm that TXA does not significantly reduce the risk of WHO grade 2 or higher bleeding, nor does it decrease the need for platelet transfusions.
HEMATOPOIESIS AND STEM CELLS
Physioxia-induced downregulation of Tet2 in hematopoietic stem cells contributes to enhanced self-renewal
Aljoufi et al examined the mechanistic basis for the negative impact of ambient air on hematopoietic stem cell (HSC) self-renewal when compared to physioxia. RNA profiling delineated a role for Tet2, which is upregulated in ambient air, leading to downregulation of self-renewal genes. Loss of Tet2 rescues HSCs from sensitivity to changes in oxygen tension, suggesting a novel molecular program that may be exploited to improve ex vivo HSC expansion.
LYMPHOID NEOPLASIA
DNMT3A mutations define a unique biological and prognostic subgroup associated with cytotoxic T cells in PTCL-NOS
MYELOID NEOPLASIA
Whole-genome CRISPR screening identifies N-glycosylation as a genetic and therapeutic vulnerability in CALR-mutant MPNs
Calreticulin (CALR) mutations are important disease-initiating drivers of myeloproliferative neoplasms (MPNs) and cause hyperproliferation by binding to the thrombopoietin (TPO) receptor and inducing cytokine independent signaling. Jutzi and colleagues report on a CRISPR knockout screen in CALR-mutant cells to identify potential targeted approaches to treating CALR-mutant MPNs. They demonstrated that N-glycosylation of the TPO receptor is necessary for normal surface receptor expression. Chemical inhibition of N-glycosylation impairs growth of CALR-mutant cells but not normal cells, providing a potential for targeted therapy of CALR-mutant MPNs.
TRANSPLANTATION
Immune landscape after allo-HSCT: TIGIT- and CD161-expressing CD4 T cells are associated with subsequent leukemia relapse
Clinical Trials & Observations
LETTER TO BLOOD
Early initiation of disease-modifying therapy can impede or prevent diffuse myocardial fibrosis in sickle cell anemia
Clinical Trials & Observations
Cardiovascular disease is a major cause of mortality in patients with sickle cell disease (SCD). Niss et al previously reported that cardiac magnetic resonance in 25 patients showed universal myocardial fibrosis, which they correlated with increased extracellular volume fraction (ECV). In the current study, they compared patients with SCD who were treated with hydroxyurea or transfusion at age <6 years to a group of patients with SCD without therapy. They documented that patients treated early had ECV levels comparable to normal controls, potentially preventing subsequent myocardial fibrosis.
BLOOD WORK
ERRATA
-
Cover Image
Cover Image
![issue cover]()
This highly proliferative B-cell lymphoma, composed of large, transformed B cells mainly resembling pleomorphic centroblasts, displays many mitotic figures and a complex karyotype but has no rearrangements of MYC or BCL2. This composition is illustrative of diffuse large B-cell lymphoma, not otherwise specified, according to the International Consensus Classification of mature lymphoid neoplasms. See the article by Campo et al on page 1229.
- PDF Icon Front MatterFront Matter
- PDF Icon Table of ContentsTable of Contents
- PDF Icon Back MatterBack Matter
- PDF Icon Editorial BoardEditorial Board
Advertisement intended for health care professionals
Email alerts
Advertisement intended for health care professionals

Tranexamic acid as a stopgap for low platelets?
Clinical Trials & Observations